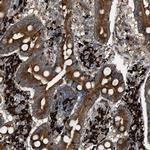
BAIAP2L1 Antibody in Immunohistochemistry (IHC)

Search
Invitrogen
BAIAP2L1 Polyclonal Antibody
{{$productOrderCtrl.translations['antibody.pdp.commerceCard.promotion.promotions']}}
{{$productOrderCtrl.translations['antibody.pdp.commerceCard.promotion.viewpromo']}}
{{$productOrderCtrl.translations['antibody.pdp.commerceCard.promotion.promocode']}}: {{promo.promoCode}} {{promo.promoTitle}} {{promo.promoDescription}}. {{$productOrderCtrl.translations['antibody.pdp.commerceCard.promotion.learnmore']}}
产品信息
PA5-54365
种属反应
宿主/亚型
分类
类型
抗原
偶联物
形式
浓度
规格
纯化类型
保存液
内含物
保存条件
运输条件
RRID
产品详细信息
Immunogen sequence: LLSFAQGDVI TLLIPEEKDG WLYGEHDVSK ARGWFPSSYT KLLEENETEA VTVPTPSPTP VRSISTVNLS EN
Highest antigen sequence identity to the following orthologs: Mouse - 85%, Rat - 82%.
靶标信息
This gene encodes a member of the IMD (IRSp53/MIM homology domain) family. Members of this family can be subdivided in two groups, the IRSp53-like and MIM-like, based on the presence or absence of the SH3 (Src homology 3) domain. The protein encoded by this gene contains a conserved IMD, also known as F-actin bundling domain, at the N-terminus, and a canonical SH3 domain near the C-terminus, so it belongs to the IRSp53-like group. This protein is the substrate for insulin receptor tyrosine kinase and binds to the small GTPase Rac. It is involved in signal transduction pathways that link deformation of the plasma membrane and remodeling of the actin cytoskeleton. It also promotes actin assembly and membrane protrusions when overexpressed in mammalian cells, and is essential to the formation of a potent actin assembly complex during EHEC (Enterohemorrhagic Escherichia coli) pedestal formation.
仅用于科研。不用于诊断过程。未经明确授权不得转售。
篇参考文献 (0)
生物信息学
蛋白别名: BAI1 associated protein 2 like 1; BAI1-associated protein 2-like protein 1; BAR/IMD domain-containing adapter protein 2-like 1; Brain-specific angiogenesis inhibitor 1-associated protein 2-like protein 1; Insulin receptor tyrosine kinase substrate; IRTKS; unnamed protein product
基因别名: 1300006M19Rik; AI585895; BAIAP2L1; IRTKS; RGD1308452
UniProt ID: (Human) Q9UHR4, (Mouse) Q9DBJ3, (Rat) Q3KR97
Entrez Gene ID: (Human) 55971, (Mouse) 66898, (Rat) 304282